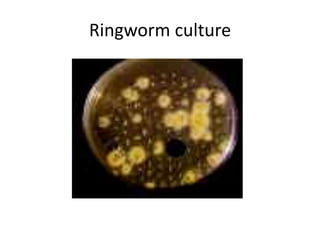
Ringworm culture

1. Cutaneous mycoses are infections of the skin, hair, or nails caused by a group of fungi called dermatophytes that digest keratin.
2. Dermatophytosis, commonly known as ringworm, is caused by three genera of dermatophytes - Trichophyton, Microsporum, and Epidermophyton - and can infect different areas of the body like the feet, nails, scalp, or beard.
3. Dermatophytes are classified ecologically into anthropophilic, zoophilic, and geophilic types depending on their usual habitat of humans, animals, or soil respectively in order to determine the likely source of infection.